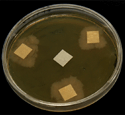
ひかり菌

商品カテゴリー
- キョーリン
- 商品情報
- 咲ひかり・咲ひかり金魚(餌・エサ)
- 濾材の汚れ実験
ひかり菌について
生菌剤(ひかり菌)とその働き
一般的に、生菌剤と呼ばれるものは消化管内において有用に作用する生きた微生物のことを指し、ヨーグルトやヤクルトなど人間の健康食品として注目されているものから畜産・水産で使用されているものまで様々です。その中でも弊社が注目したのが、ひかり菌と呼んでいるバチルス菌の一種です。
咲ひかりには休眠状態、つまり活動を停止した状態で生菌剤が添加されておりますが、このままでは効果を示しません。 しかし、魚に摂餌され、腸内に届くと徐々に活性化して腸内細菌の中で優占種となり、腸内を正常に保つ効果を発揮します。
また、排泄された糞中にも菌の一部が残っており、糞中の有機物を分解して濾過槽のバクテリアの負担を軽減します。この一連の流れを模式化すると下記のような図になります。

- 腸内にひかり菌が住み着き、粒を消化しやすい形に分解する。
- 腸内で優占種となり、錦鯉の健康をサポートする。
- 糞を分解し、ヘドロの量が減り、水質が安定する上にろ過材の洗浄が楽になる
ひかり菌が他の魚病菌よりも優先的に増殖しました
ひかり菌入り飼料と無添加の飼料をらんちゅうに与え、各々排泄した糞を取りだし、試験管にて分解速度を確認したところ、ひかり菌を添加した区は右の写真のようにわずか1日で糞が分解され、粉状になることが確認されました。これは恐らく、腸内で優占種となったひかり菌が糞と一緒に排泄され、糞中の有機物を分解したためと思われます。

プロバイオティクス(※1)に必要な“ひかり菌”(※2)を検査しています
穴あき病などを引き起こすエロモナス菌とひかり菌をシャーレに培養しました。四角い紙にひかり菌を染みこませ、培地の上に置いています。エロモナス菌が増殖しているのが茶色く見える部分です。シャーレ全体に茶色く見える部分にエロモナス菌が増殖しています。
ひかり菌の周りでは茶色が薄くなっており、ひかり菌がエロモナス菌を押しのけ増殖している事が分かります。(中央の紙はひかり菌を染みこませていません)
エロモナス菌以外にシュードモナス菌やエドワジエラ菌などの魚病菌に対しても、同様にひかり菌が優占種として増殖しました。
プロバイオティクスとは(※1)
微生物により消化器内の細菌叢を改善し、ヒト他動物など宿主に有益な作用をもたらしうる有用な微生物とそれらの増殖促進物質。人用にはヨーグルトや乳酸飲料が代表的。
ひかり菌(※2)
バチルス属の一種で魚の腸内に入ると優占種となり、腸内環境を整えます。
濾材の汚れ実験
生菌剤(ひかり菌)の効果その1

採取1日後の糞の様子
左)ひかり菌添加区
右)ひかり菌無添加区
ひかり菌無添加区はまだ糞の形状を保っているが、添加区は粉状に分解されている
糞の分解促進について
ひかり菌入り飼料と無添加の飼料をらんちゅうに与え、各々排泄した糞を取りだし、試験管にて分解速度を確認したところ、ひかり菌を添加した区は右の写真のようにわずか1日で糞が分解され、粉状になることが確認されました。これは恐らく、腸内で優占種となったひかり菌が糞と一緒に排泄され、糞中の有機物を分解したためと思われます。

育1ヶ月後のろ材の様子
左)ひかり菌添加区
右)ひかり菌無添加区
ろ材の目詰まりについて
次に、ひかり菌添加飼料と無添加飼料をそれぞれ一定期間与えて、ろ材の汚れ具合を調べてみました。らんちゅうを約1ヶ月飼育した後、ろ材を取り出してみるとひかり菌を添加していない区のほうが汚泥が多くなっていました。

ろ材に付着した汚泥量
左)ひかり菌添加区
右)ひかり菌無添加区
ろ材の目詰まりについて
さらに、各ろ材を一定量の水でもみ洗いし、その後汚泥を沈殿させてその体積を測定したところ、ひかり菌を添加した区での汚泥量は添加していない区よりも4割程度減少していることがわかりました。
生菌剤(ひかり菌)の効果その2
同じ原料の飼料にひかり菌を添加することによって飼料効率がどう変化するか調べました。
以下は、試験用に特別に製造した飼料での試験であり、「咲ひかり金魚 色揚用」の結果ではありません。

- 飼育水槽:60cm水槽
- 飼育期間:21日間
- 供試魚:ランチュウ(各区6匹)
- 給餌:魚体重の2%
この試験により、飼料効率に数%の改善が見られました。ひかり菌によって餌の消化吸収が助けられたためでしょう。しかし、魚体にストレスや環境負担が掛かっていない状態ではこの効果が見られないことがあります。負担が少ない状態では、ひかり菌の助けを借りることなく、魚自体の消化吸収酵素だけでも十分吸収が行われると考えられるからです。実際、上記の試験では、給餌量を多めに設定し、通常飼育よりも負荷を大きくしていたためこのようにはっきりした結果になったと考えられます。
| ひかり菌配合飼料ラインナップ | 商品名 |
|---|---|
| 錦鯉用飼料 | 姫ひかり |
| 金魚用飼料 | ゴールドプロス |
| プロリア色揚 | |
| きんぎょのえさ5つの力 | |
| 熱帯魚用飼料 | ネオプロス |
| ネオプロスグッピー | |
| クレストフリーク | |
| メダカ・川魚用飼料 | ひかりタナゴ |
| メダカプロス | |
| メダカの舞 | |
| 日淡プロス | |
| カメ用飼料 | カメプロス |
| 両生類・爬虫類用飼料 | フトアゴドライ |
| マルベリックドライ・マルベリックドライ大粒 | |
| レオパドライ | |
| モニタードライ | |
| 小動物用飼料 | ひかりハリネズ |
| ひかりデグデグ | |
| デグデグソフト | |
| ひかりハムハム | |
| ひかりチチララ | |
| ひかりモモン | |
| 鳥用飼料 | キラピピ |
| その他飼料 | ザリガニのエサ にごり・ニオイ対策用 |
| パラクリア | |
関連情報
関連商品
関連リンク
商品一覧
- 新商品ランナップ
- 錦鯉用飼料
- 金魚用飼料
- 熱帯魚用飼料
- 咲ひかり
- メダカ・川魚用飼料
- 海水魚用飼料
- 冷凍・天然飼料
- 両生類・爬虫類用飼料
- 小動物用飼料
- 鳥用飼料
- その他飼料
- 観賞魚用器具類・薬品
- 商品一覧から探す
- 販売終了商品(2005~)